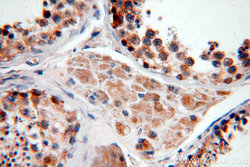

Antibody data
- Antibody Data
- Antigen structure
- References [3]
- Comments [0]
- Validations
- Western blot [1]
- Immunohistochemistry [2]
Submit
Validation data
Reference
Comment
Report error
- Product number
- 20374-1-AP - Provider product page

- Provider
- Proteintech Group
- Proper citation
- Proteintech Cat#20374-1-AP, RRID:AB_10973680
- Product name
- USP50 antibody
- Antibody type
- Polyclonal
- Description
- USP50 antibody (Cat. #20374-1-AP) is a rabbit polyclonal antibody that shows reactivity with human, mouse, rat and has been validated for the following applications: IF, IHC, WB, ELISA.
- Reactivity
- Human, Mouse, Rat
- Host
- Rabbit
- Conjugate
- Unconjugated
- Isotype
- IgG
- Vial size
- 20ul, 150ul
Submitted references Vitamin C promotes ACE2 degradation and protects against SARS-CoV-2 infection.
Mitochondrial STAT3 exacerbates LPS-induced sepsis by driving CPT1a-mediated fatty acid oxidation.
Induction of deubiquitinating enzyme USP50 during erythropoiesis and its potential role in the regulation of Ku70 stability.
Zuo Y, Zheng Z, Huang Y, He J, Zang L, Ren T, Cao X, Miao Y, Yuan Y, Liu Y, Ma F, Dai J, Tian S, Ding Q, Zheng H
EMBO reports 2023 Apr 5;24(4):e56374
EMBO reports 2023 Apr 5;24(4):e56374
Mitochondrial STAT3 exacerbates LPS-induced sepsis by driving CPT1a-mediated fatty acid oxidation.
Li R, Li X, Zhao J, Meng F, Yao C, Bao E, Sun N, Chen X, Cheng W, Hua H, Li X, Wang B, Wang H, Pan X, You H, Yang J, Ikezoe T
Theranostics 2022;12(2):976-998
Theranostics 2022;12(2):976-998
Induction of deubiquitinating enzyme USP50 during erythropoiesis and its potential role in the regulation of Ku70 stability.
Cai J, Wei J, Schrott V, Zhao J, Bullock G, Zhao Y
Journal of investigative medicine : the official publication of the American Federation for Clinical Research 2018 Jan;66(1):1-6
Journal of investigative medicine : the official publication of the American Federation for Clinical Research 2018 Jan;66(1):1-6
No comments: Submit comment
Supportive validation
- Submitted by
- Proteintech Group (provider)
- Main image

- Experimental details
- mouse brain tissue were subjected to SDS PAGE followed by western blot with 20374-1-AP(USP50 antibody) at dilution of 1:300
- Sample type
- tissue
Supportive validation
- Submitted by
- Proteintech Group (provider)
- Main image

- Experimental details
- Immunohistochemical of paraffin-embedded human testis using 20374-1-AP(USP50 antibody) at dilution of 1:50 (under 10x lens)
- Sample type
- tissue
- Submitted by
- Proteintech Group (provider)
- Main image
- Experimental details
- The USP50 antibody from Proteintech is a rabbit polyclonal antibody to a peptide of human USP50. This antibody recognizes human,mouse,rat antigen. The USP50 antibody has been validated for the following applications: ELISA, WB, IHC analysis.